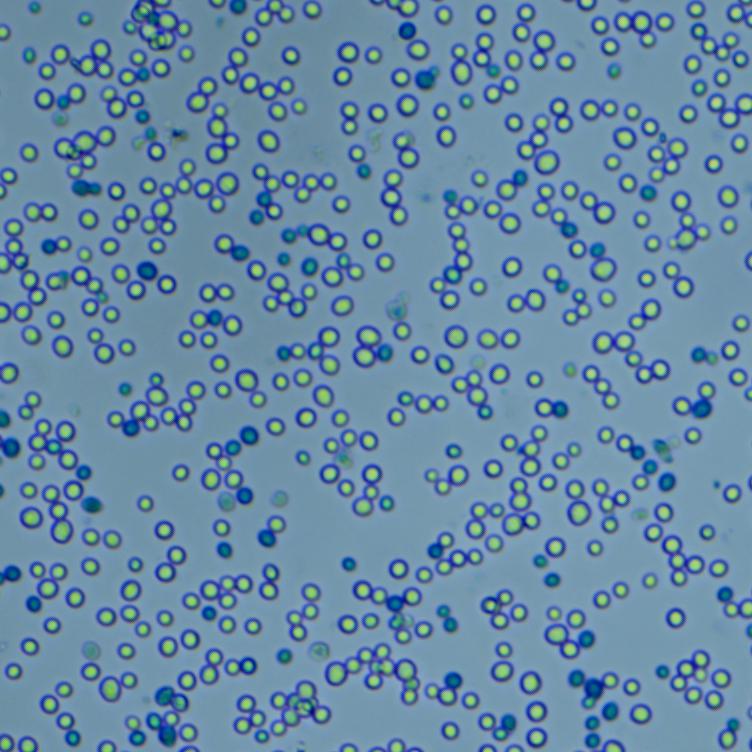

这是一款专业的全自动酵母细胞计数仪,它参考《国标:GB/T20886-2007,食品加工用酵母》计数规则,使用亚甲基蓝染色的方法,结合先进的光学系统和智能图像识别技术,对直径≥1μm的酵母细胞进行总数和死活状态分析。不仅图像识别效果很好,并且可通过仪器自带的比对功能,追溯与核对计数结果的准确性,大大提升结果可信度与用户体验感。
全自动酵母细胞计数仪:型号JSY-SC-034

功能特点
01- 标准化计数方法
全自动酵母细胞计数仪-依据国标GB/T 20886- 2007设计,采用标准酵母细胞计数方法,实现标准5个区域采集计数。

02- 可识别酵母细胞死活状态
全自动酵母细胞计数仪配有100万级像素彩色成像技术,更清晰的成像品质,40倍光学放大,可自动判读直径≥1um酵母细胞,检测酵母细胞的活率。

酵母细胞原始图 酵母细胞原始图
02- 干湿酵母两种结果表现形式
针对干酵母和湿酵母,其结果有两种表现形式可选,di一种按照细胞密度进行表述(个/g),第二种按照细胞浓度进行表述(个/mL)。

数据输出方式:支持Excel、PDF、JPG、TIFF(用户可选)输出方式
04-智能化设计
全自动酵母细胞计数仪设计简单明了,用户只需选择模式—插入细胞计数片—点击计数,仪器自动完成采集、识别、分析、储存和生成报告。全程自动化,无需人为干预。

05-符合FDA 21CFR Part 11要求
全自动酵母细胞计数仪软件系统的数据管理符合FDA 21CFR Part 11要求,系统实行用户权限分级管理,设置安全用户登录系统、用户登记权限管理、电子记录及电子签名,保证数据结果的可靠性和可追溯性。







